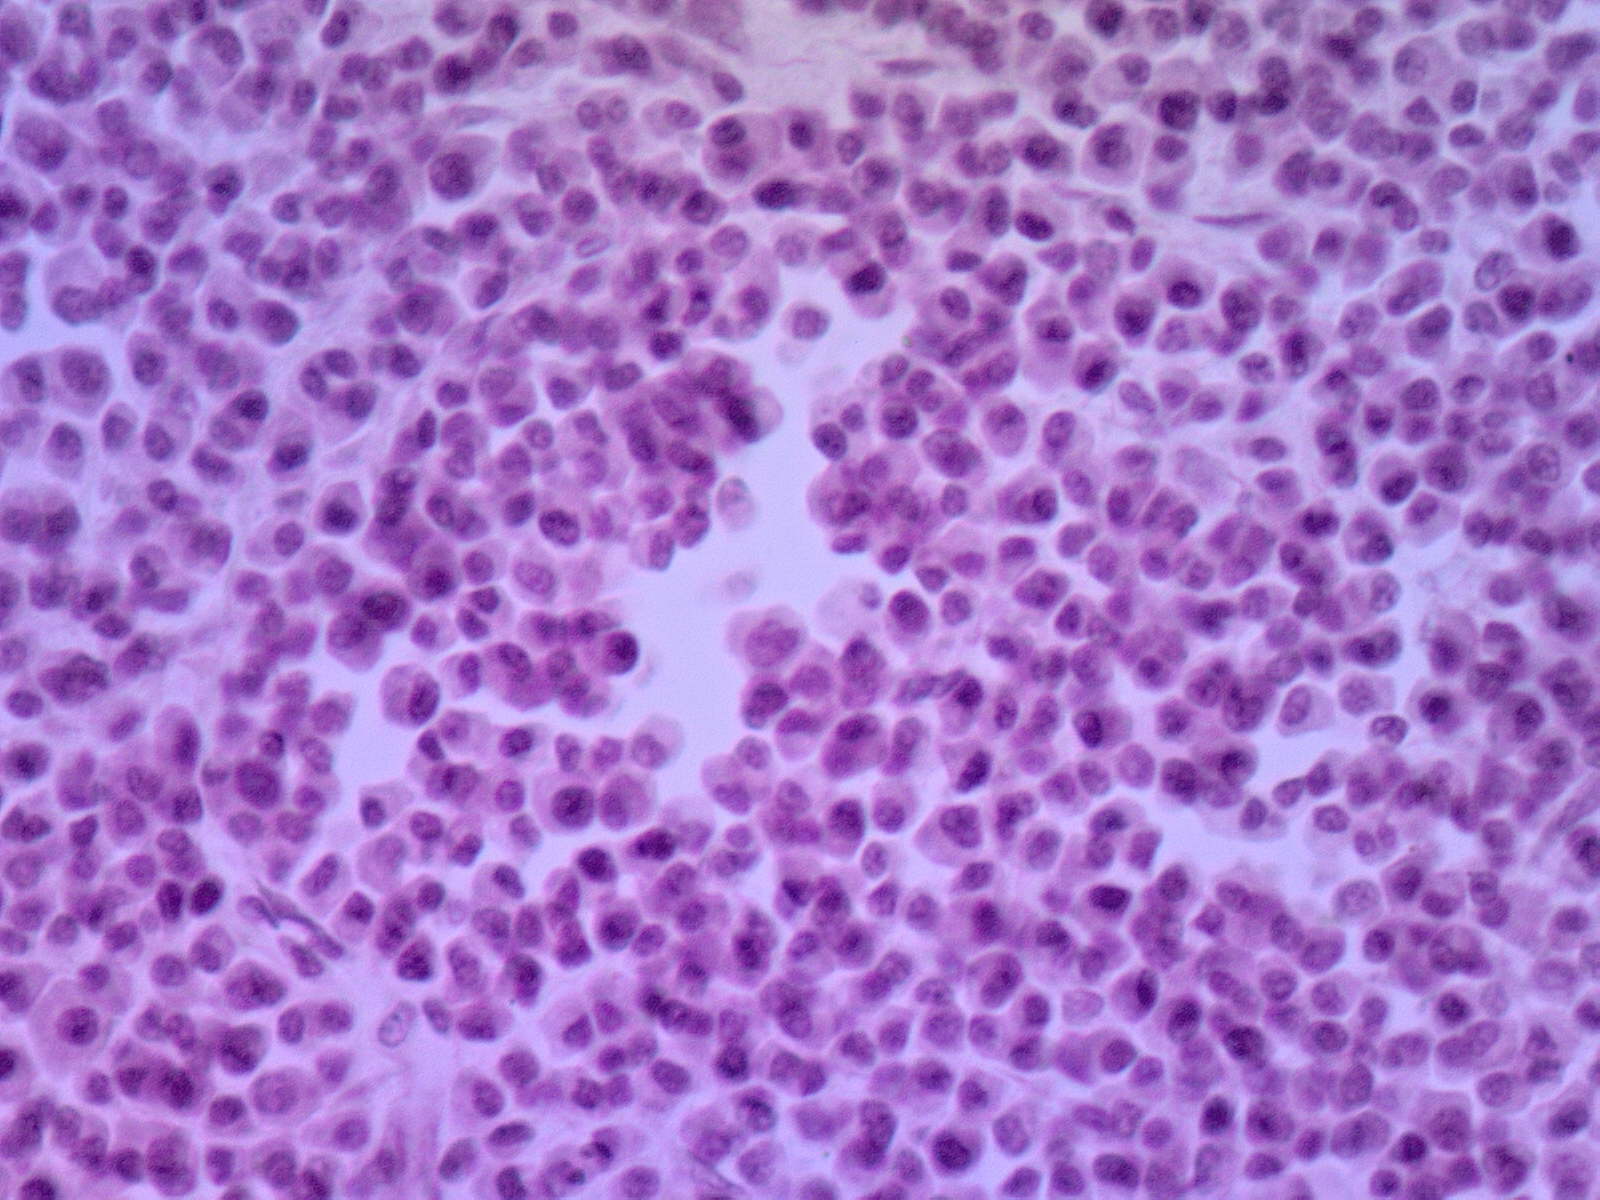

Материал: Задание+12.+Эпителиальные+опухоли
ФГБОУ ВО «УРАЛЬСКИЙ ГОСУДАРСТВЕННЫЙ МЕДИЦИНСКИЙ УНИВЕРСИТЕТ»
Министерства здравоохранения Российской Федерации
Кафедра патологической анатомии и судебной медицины
«Утверждаю»
Заведующий кафедрой
Д.м.н., проф. ____________ Л.М. Гринберг
«____» ______________________ 20___ год
МЕТОДИЧЕСКАЯ РАЗРАБОТКА К ПРАКТИЧЕСКОМУ ЗАНЯТИЮ для студентов
(учебное задание)
ООП специальности 31.05.02 «Педиатрия»
Дисциплина Б1.Б.22 «Патологическая анатомия, клиническая патологическая анатомия»
ТЕМА ЗАНЯТИЯ: Эпителиальные опухоли. Опухолевые заболевания кроветворной и лимфатической ткани.
УЧЕБНАЯ ЦЕЛЬ ЗАНЯТИЯ: Изучение клинико-морфологической сущности эпителиальных опухолей (доброкачественных и злокачественных). Изучение клинико-морфологической сущности опухолей кроветворной и лимфоидной ткани.
ЗАДАЧИ ЗАНЯТИЯ:
Студент должен знать:
- эпителиальные опухоли: понятие, сущность, биологическое значение;
- морфогенез предопухолей и эпителиальных опухолей;
- общую характеристику эпителиальных опухолей;
- классификацию эпителиальных опухолей;
- разновидности и характеристику органонеспецифических и органоспецифических опухолей;
- гемобластозы: понятие, сущность, биологическое значение;
-общую характеристику гемоблпстозов: первично-системных опухолей (лейкозов) и первично-локальных опухолей (неходжкинских лимфом и лимфомы Ходжкина);
- морфологические особенности неходжкинских лимфом и лимфомы Ходжкина;
- морфологические изменения в органах и тканях при гемобластозах;
- осложнения и причины смерти больных с опухолями кроветворной и лимфатической ткани.
Студент должен уметь:
- работать с увеличительной техникой (микроскоп);
- описывать гистологические и морфологические изменения в изучаемых препаратах;
- определять макроскопические и микроскопические отличия доброкачественной эпителиальной опухоли от рака;
-определять морфологические и гистологические изменения при лейокзах и лимфомах (Ходжкинскина и неходжкинских лимфомах);
- объяснять причины геморрагических и некротических осложнений в органах и тканях при лейкозах и при генерализации лимфом.
шифр |
Содержание компетенции |
знать |
уметь |
владеть |
ОК-1 |
способностью к абстрактному мышлению, анализу, синтезу |
анатомо-физиологические, возрастно-половые и индивидуальные особенности строения и развития организма человека; понятия этиологии, патогенеза, морфогенеза, патоморфоза эпителиальных опухолей и гемобластозов, принципы классификации эпителиальных опухолей и гемобластозов; основные понятия общей нозологии; функциональные системы организма человека, их регуляция и саморегуляция при воздействии с внешней средой в норме и патологии; структурные и функциональные основы опухолей и гемобластозов; причины, основные механизмы развития и исходов эпителиальных опухолей и гемобластозов,нарушений функций органов и систем
|
пользоваться учебной, научной, научно-популярной литературой, сетью Интернет для профессиональной деятельности; работать с увеличительной техникой (микроскопами, оптическими лупами); оценить гистофизиологическое состояние различных клеточных, тканевых и органных структур; описывать морфологические изменения изучаемых макроскопических, микроскопических препаратов и электроннограмм; визуально оценивать и протоколировать изменения в органах и тканях трупа, обосновать характер эпителиальной опухоли и гемобластозов и их клинические проявления; дать заключение о причине смерти и сформулировать патологоанатомический диагноз; заполнять медицинское свидетельство о смерти
|
медико-функциональным понятийным аппаратом; навыками микроскопирования и анализа гистологических препаратов и электронных микрофотографий; навыками постановки предварительного диагноза на основании результатов лабораторного и инструментального обследования пациентов навыками сопоставления морфологических и клинических проявлений эпителиаьной опухоли и гемобластозов; методами клинико-анатомического анализа вскрытия, исследования биопсийного и операционного материала.
|
ОК- 2 |
способностью использовать основы философских знаний для формирования мировоззренческой позиции |
|||
ОК- 5 |
готовностью к саморазвитию, самореализации, самообразованию, использованию творческого потенциала |
|||
ОК-8 |
готовностью к работе в коллективе, толерантно воспринимать социальные, этнические, конфессиональные и культурные различия |
|||
ОПК-1 |
готовностью решать стандартные задачи профессиональной деятельности с использованием информационных, библиографических ресурсов, медико-биологической терминологии, информационно-коммуникационных технологий и учетом основных требований информационной безопасности |
|||
ОПК-3 |
способностью использовать основы экономических и правовых знаний в профессиональной деятельности |
|||
ОПК-4 |
способностью и готовностью реализовать этические и деонтологические принципы в профессиональной деятельности |
|||
ОПК- 6 |
готовностью к ведению медицинской документации |
|||
ОПК-9 |
способностью к оценке морфофункциональных, физиологических состояний и патологических процессов в организме человека для решения профессиональных задач |
|||
ПК-5 |
готовностью к сбору и анализу жалоб пациента, данных его анамнеза, результатов осмотра, лабораторных, инструментальных, патолого-анатомических и иных исследований в целях распознавания состояния или установления факта наличия или отсутствия заболевания |
|||
ПК-6 |
способностью к определению у пациентов основных патологических состояний, симптомов, синдромов заболеваний, нозологических форм в соответствии с Международной статистической классификацией болезней и проблем, связанных со здоровьем - X пересмотр, принятой 43-ей Всемирной Ассамблеей Здравоохранения, г. Женева, 1989 г. |
|||
ОК-1 |
способностью к абстрактному мышлению, анализу, синтезу |
|
|
|
ОК- 2 |
способностью использовать основы философских знаний для формирования мировоззренческой позиции |
ПРОДОЛЖИТЕЛЬНОСТЬ ЗАНЯТИЯ: 3 часа
МЕСТО ПРОВЕДЕНИЯ ЗАНЯТИЯ : учебная комната
КОНТРОЛЬНЫЕ ВОПРОСЫ ПО ТЕМЕ:
Для успешной работы на практическом занятии необходимо :
Проработать тренировочные тесты по теме занятия на сайте кафедры;
Дигностировать микропрепараты по теме занятия на сайте кафедры.
Подготовить теоретический материал :
- Номенклатура и классификация эпителиальных опухолей.
- Виды и разновидности эпителиальных органонеспецифических и органоспецифических опухолей
- Общие положения и принципы классификации опухолей кроветворной и лимфоидной ткани.
- Лейкозы. Определение. Этиология, эпидемиология. Принципы классификации. Методы диагностики.
- Особенности течения острого и хронического лейкоза.
- Лимфомы. Определение. Принципы классификации лимфом.
- Методы диагностики лимфом. Лейкемизация лимфом.
- Лимфома Ходжкина (син. Лимфогрануломатоз, ЛГМ). Макроскопическая и микроскопическая диагностика ЛГМ. Гистологические варианты ЛГМ.
- Осложнения и причины смерти больных при лейкозах и лимфомах.
ЗАДАНИЯ И МЕТОДИЧЕСКИЕ УКАЗАНИЯ К ИХ ВЫПОЛНЕНИЮ
На занятии студенту необходимо выполнить:
1. Ответить на входного тест-контроля
2. Ответить на вопросы преподавателя
3. Принять участие в обсуждении
4. Изучить таблицы: 58, 59, 60, 62, 63, 64
5. Описать по схеме и сделать заключение по макропрепаратам:.
№ 364 , 355 , 362 , 324 , 426, 431 , 433/79 , 284/436 , 432
6. Изучить, зарисовать и отметить существенные элементы на микропрепаратах:
№ 94 –Плоскоклеточный ороговевающий рак кожи
В коже видны различные по величине и форме опухолевые тяжи из многослойного плоского эпителия. В центральных отделах некоторых опухолевых разрастаний определяются розовые концентрические структуры, которые формируются из ороговевающих клеток. Это раковые «жемчужины». На большем увеличении можно отметить полиморфизм опухолевых клеток. В окружающей соединительной ткани обильная клеточная инфильтрация.
Существенные элементы: 1. опухолевые разрастания
2. раковые «жемчужины»
3. клеточная инфильтрация стромы

№ 91 – Фиброаденома молочной железы
Железы различной величины и формы окружены соединительной тканью. Некоторые железы деформированы за счет неравномерного разрастания соединительной ткани особенно в сторону просвета желез. Это интраканаликулярный компонент фиброаденомы. Вокруг некоторых округлых желез соединительная ткань разрослась кольцевидно. Это периканаликулярный компонент. На большем увеличении — эпителий желез одно- и двурядный, расположен на базальной мембране, а в соединительной ткани видны фибробласты и фиброциты.
Существенные элементы: 1. опухолевые железы
2. интраканаликулярный компонент
3. периканаликулярный компонент


№ 92 – Базалиома кожи
В коже отмечается погружного характера разрастание клеток в виде тяжей и комплексов. На большем увеличении — клетки мелкие, с небольшим количеством цитоплазмы и темным округлым, овальным или вытянутым ядром. Клетки напоминают базальный слой эпидермиса. В наружном слое опухолевых разрастаний клетки расположены частоколом, во внутренних отделах хаотично. В клетках видны фигуры деления ядер — митозы.
Существенные элементы: 1. тяжи и комплексы опухолевого эпителия
2. частокольный слой клеток
3. фигуры митозов

№ 87 – Папиллома гортани
В препарате видны разрастания многослойного плоского неороговевающего эпителия и соединительной ткани сосочкового характера. В эпителии паракератоз — пролиферативное утолщение эпителиального пласта. Сосочковые разрастания встречаются кругло-овальной и причудливой формы, что связано с различным направлением среза.
Существенные элементы: 1. эпителиальные сосочковые разрастания
2. строма сосочков

№ 174 - Лимфогрануломатоз
Структура лимфатического узла утрачена, лимфатические фолликулы отсутствуют, видны поля склероза. На большем увеличении определяются крупные базофильные клетки с большим гиперхромным ядром — клетки Ходжкина; гигантские клетки с центральным расположением двух и более ядер — клетки Березовского—Штернберга; эозинофилы; ретикулярные и лимфоидные клетки, нейтрофилы. Встречаются очаги некроза.
Существенные элементы: 1. клетки Ходжкина
2. клетки Березовского—Штернберга
3. эозинофилы
4. очаги некроза
5. поля склероза


№ 173 – Плазмоцитома
В гистологическом срезе определяется диффузно разросшиеся плазматические клетки разнообразного вида. В основном они содержат темно-окрашенные эксцентрично расположенные ядра и довольно обильную базофильную цитоплазму. Видны ядра с тонкой структурой хроматина и бледной цитоплазмой.
Существенные элементы: 1. поля плазматических клеток
№ 168 - Миокард при лейкозе
Структура миокарда и эндокарда сохранена. В строме миокарда и в толще эндокарда имеются лейкемические инфильтраты из низкодифференцированных клеток. На большем увеличении — инфильтраты состоят из миелоподобных низкодифференцированных клеток. Их ядра крупные, неправильной формы, ободок цитоплазмы узкий.
Существенные элементы: 1. лейкемические инфильтраты в строме миокарда
2. лейкемические инфильтраты в эндокарде
3. опухолевые полиморфные клетки


ОЦЕНИВАНИЕ ЗНАНИЙ, УМЕНИЙ, НАВЫКОВ ПО ТЕМЕ ЗАНЯТИЯ
ПРАКТИЧЕСКОЕ ЗАНЯТИЕ – max 2,5 балла:
за тест: 1 б. – оц.-5; 0,7 б. – оц.-4; 0,5б. – оц.-3.
за устный ответ: 1 б. – оц.-5; 0,7 б. – оц.-4; 0,5б. – оц.-3.
Отчет по практической части занятия, по лекции – 0,5 балла
УЧЕБНО-ИССЛЕДОВАТЕЛЬСКАЯ РАБОТА:
Доклады по темам:
« Исторические аспекты изучения опухолей»
«Морфологические аспекты прижизненной верификации опухолевых поражений»
«Роль иммуногистохимии в определении гистогенеза опухолей лимфоидной ткани»
ЛИТЕРАТУРА ДЛЯ ПОДГОТОВКИ К ЗАНЯТИЮ :
Основная:
Лекционный материал
Патология. Под редакцией М.А. Пальцева. – М: «Медицина». – 2017. – В 2 томах.
Зайратьянц О.В. Патологическая анатомия. Атлас
Дополнительная:
учебник «Патологическая анатомия», 2017, Т.2, часть 1,
Методическая разработка подготовлена доцентом, к.м.н. А.С. Филатовой
Обсуждена на заседании кафедры № ____ от «___» _______________ 20___ г.